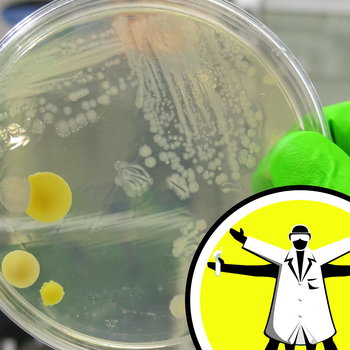

The Naked Scientists Podcast - Stripping Down Science
The Naked Scientists flagship science show brings you a lighthearted look at the latest scientific breakthroughs, interviews with the world's top scientists, answers to your science questions and science experiments to try at home.